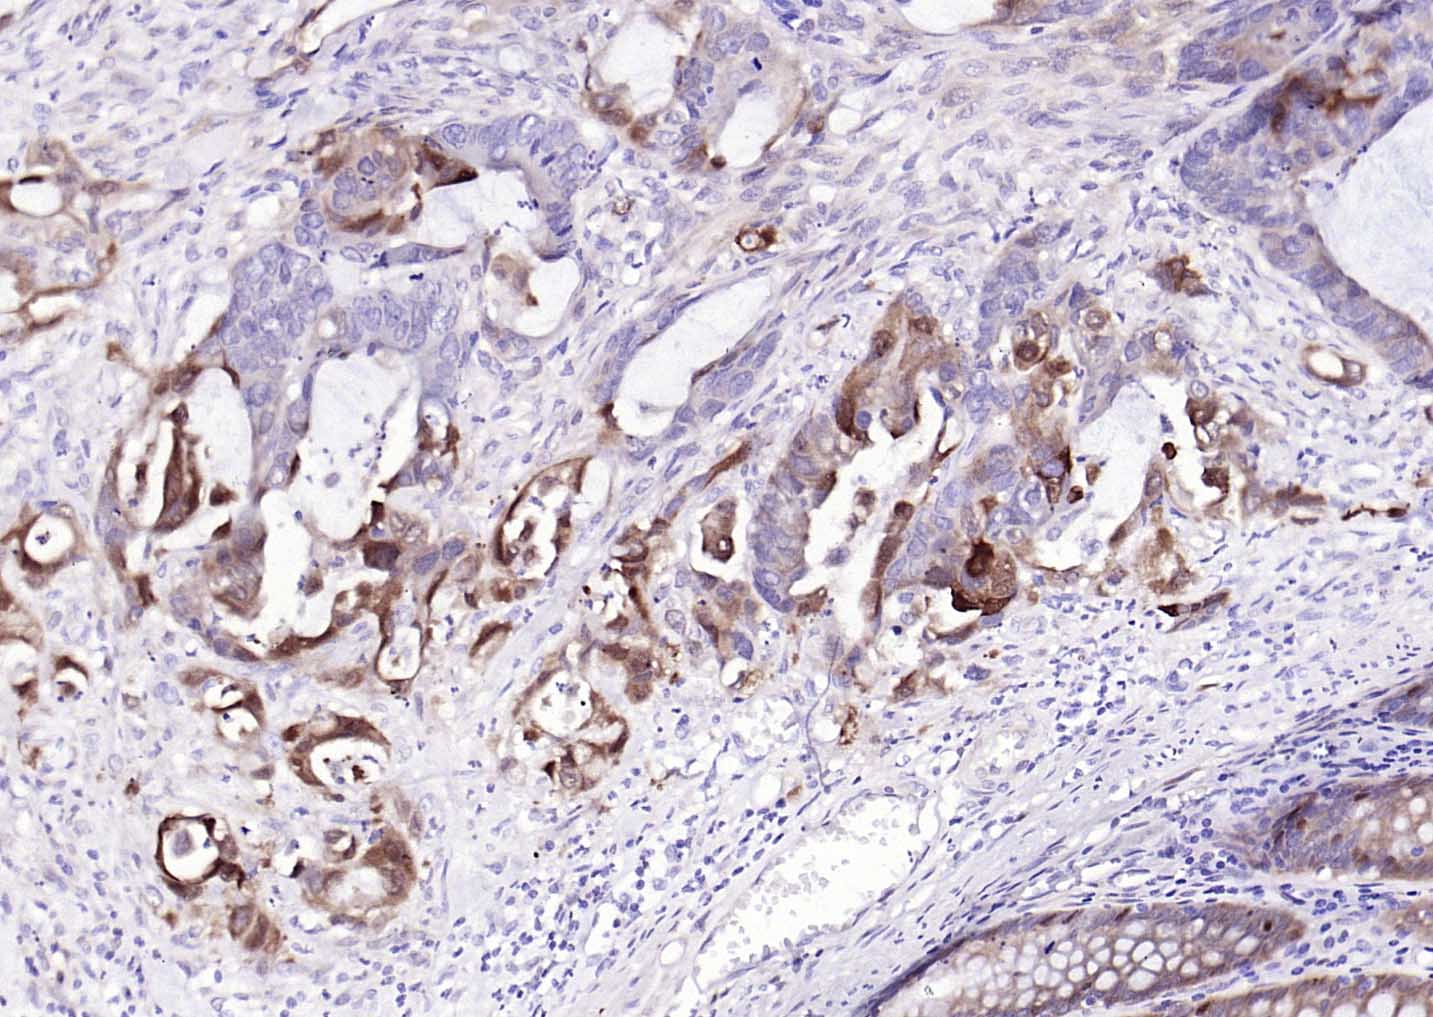
产品细节图片2

相关产品推荐更多 >
万千商家帮你免费找货
0 人在求购买到急需产品
- 详细信息
- 文献和实验
- 技术资料
- 应用范围:
产品信息以Bioss网站为准
- 规格:
50ul/100ul
| 规格: | 50ul | 产品价格: | ¥1400.0 |
|---|---|---|---|
| 规格: | 100ul | 产品价格: | ¥2500.0 |
| 产品编号 | bsm-54196R |
| 英文名称 | BST2 Recombinant Rabbit mAb |
| 中文名称 | 骨髓基质干细胞抗原2重组兔单抗 |
| 英文别名 | Bone marrow stromal antigen 2; Bone marrow stromal cell antigen 2; Bone marrow stromal cell antigen; BST 2; BST-2; BST2_HUMAN; CD 317; CD317; CD317 antigen; HM1.24 antigen; NPC A 7; Tetherin. |
| 产品应用 | WB=1:500-2000, IHC-P=1:50-200, IHC-F=1:50-200, IF=1:100-500, Flow-Cyt=1:50-200 Not yet tested in other applications. |
| 交叉反应 | Human |
| 抗体来源 | Rabbit |
| 免疫原 | KLH conjugated synthetic peptide derived from human BST2 |
| 亚型 | IgG |
| 性状 | Liquid |
| 纯化方法 | affinity purified by Protein A |
| 克隆类型 | Recombinant |
| 理论分子量 | 18 kDa |
| 浓度 | 1mg/ml |
| 储存液 | 0.01M TBS (pH7.4) with 1% BSA, 0.02% Proclin300 and 50% Glycerol. |
| 研究领域 | Cardiovascular > Blood Epigenetics and Nuclear Signaling > Nuclear Signaling Pathways > NFkB pathway Immunology > Adaptive Immunity > B Cells > Non-CD Immunology > Immune System Diseases > Antiviral Signaling > HIV-related Signal Transduction > Signaling Pathway > Nuclear Signaling > NFkB Pathway Stem Cells > Hematopoietic Progenitors > Surface Molecules Tags & Cell Markers > Cell Type Markers > Other Cell Types |
| 亚基 | Parallel homodimer; disulfide-linked. May form homotetramers under reducing conditions. Dimerization is essential for its antiviral activity. Interacts (via cytoplasmic domain) with ARHGAP44 (By similarity). Interacts with MMP14 (via C-terminal cytoplasmic tail). Interacts with LILRA4/ILT7. Interacts (via transmembrane domain) with HIV-1 VPU (via transmembrane domain). Interacts with HIV-2 ENV and ebola GP protein. |
| 亚细胞定位 | Golgi apparatus; trans-Golgi network. Cell membrane. Cell membrane. Late endosome. Targeted to late endosomes upon KSHV infection and subsequent ubiquitination. Targeted to the trans-Golgi network by viral VPU protein. |
| 组织特异性 | Predominantly expressed in liver, lung, heart and placenta. Lower levels in pancreas, kidney, skeletal muscle and brain. Overexpressed in multiple myeloma cells. Highly expressed during B-cell development, from pro-B precursors to plasma cells. Highly expressed on T-cells, monocytes, NK cells and dendritic cells (at protein level). |
| 翻译后修饰 | Monoubiquitinated by KSHV E3 ubiquitin-protein ligase K5, leading to its targeting to late endosomes and degradation. The GPI anchor is essential for its antiviral activity. |
| 相似性 | Belongs to the tetherin family. |
| 功能 | IFN-induced antiviral host restriction factor which efficiently blocks the release of diverse mammalian enveloped viruses by directly tethering nascent virions to the membranes of infected cells. Acts as a direct physical tether, holding virions to the cell membrane and linking virions to each other. The tethered virions can be internalized by endocytosis and subsequently degraded or they can remain on the cell surface. In either case, their spread as cell-free virions is restricted. Its target viruses belong to diverse families, including retroviridae: Human immunodeficiency virus type 1 (HIV-1), Human immunodeficiency virus type 2 (HIV-2), simian immunodeficiency viruses (SIVs), equine infectious anemia virus (EIAV), feline immunodeficiency virus (FIV), prototype foamy virus (PFV), Mason-Pfizer monkey virus (MPMV), human T-cell leukemia virus type 1 (HTLV-1), Rous sarcoma virus (RSV) and murine leukemia virus (MLV), flavivirideae: hepatitis C virus (HCV), filoviridae: Ebola virus (EBOV) and Marburg virus (MARV), arenaviridae: lassa virus (LASV) and machupo virus (MACV), herpesviridae: kaposis sarcoma-associated herpesvirus (KSHV), rhabdoviridae: vesicular stomatitis virus (VSV), orthomyxoviridae: influenza A virus, and paramyxoviridae: Nipah virus. Can inhibit cell surface proteolytic activity of MMP14 causing decreased activation of MMP15 which results in inhibition of cell growth and migration. Can stimulate signaling by LILRA4/ILT7 and consequently provide negative feedback to the production of IFN by plasmacytoid dendritic cells in response to viral infection. Plays a role in the organization of the subapical actin cytoskeleton in polarized epithelial cells. |
| 保存条件 | Shipped at 4℃. Store at -20℃ for one year. Avoid repeated freeze/thaw cycles. |
| 注意事项 | This product as supplied is intended for research use only, not for use in human, therapeutic or diagnostic applications. |
| 背景资料 | Bone marrow stromal cells act as regulators for B-cell growth and development through their surface molecules and cytokines. Bone marrow stromal antigen-2 (BST-2), also designated CD317 antigen, is a single- pass type II membrane protein. BST-2, which is expressed mainly on synovial cell lines and bone marrow stromal cell lines, is primarily expressed in liver, heart, placenta and lung tissues. BST-2 is thought to be involved in pre-B cell growth. It has been implicated in B cell activation in rheumatoid arthritis. |
| 应用 | 推荐稀释比例 |
| {WB} | {1:500-2000} |
| {IHC-P} | {1:50-200} |
| {IHC-F} | {1:50-200} |
| {IF} | {1:100-500} |
| {Flow-Cyt} | {1:50-200} |

Lane 1: Hela cell lysate
Lane 2: Siha cell lysatee
Primary: Anti-BST2 (bsm-54196R) at 1:500 dilution
Secondary: Goat Anti-Rabbit IgG - HRP at 1:5000 dilution
Predicted band size: 18 kD
Observed band size: 40 kD

风险提示:丁香通仅作为第三方平台,为商家信息发布提供平台空间。用户咨询产品时请注意保护个人信息及财产安全,合理判断,谨慎选购商品,商家和用户对交易行为负责。对于医疗器械类产品,请先查证核实企业经营资质和医疗器械产品注册证情况。
 文献和实验
文献和实验到 PVDF 膜上,同时减少蛋白不必要降解,这对于最终获得清晰、可信结果也是需要考虑因素。抗体信息:1.ACC1, Recombinant Rabbit monoclonal IgG. HuaAn. HuaAn biotechnology , inc.2.ATGL, Mouse mAb IgG1, Cat#:RT1058. HuaAn biotechnology , inc.3.p-PERK(Thr981), Rabbit Polyclonal IgG primary antibodies, Cat
The OP9-DL1 System: Generation of T-Lymphocytes from Embryonic or Hematopoietic Stem Cells In Vitro
al. 2006b ). MATERIALS Reagents Anti-CD24 monoclonal antibody (mAb) (J11d clone) (for Protocol 3) Use either culture supernatant that contains anti-CD24 mAb or purified anti-CD24 mAb (see Step 55). BDPharmLyse (red blood cell lysing
 技术资料
技术资料暂无技术资料 索取技术资料











